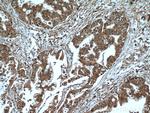
GSTO1 Antibody in Immunohistochemistry (Paraffin) (IHC (P))

Search
Proteintech
GSTO1 Polyclonal Antibody
{{$productOrderCtrl.translations['antibody.pdp.commerceCard.promotion.promotions']}}
{{$productOrderCtrl.translations['antibody.pdp.commerceCard.promotion.viewpromo']}}
{{$productOrderCtrl.translations['antibody.pdp.commerceCard.promotion.promocode']}}: {{promo.promoCode}} {{promo.promoTitle}} {{promo.promoDescription}}. {{$productOrderCtrl.translations['antibody.pdp.commerceCard.promotion.learnmore']}}
产品信息
15124-1-AP
种属反应
已发表种属
宿主/亚型
分类
类型
抗原
偶联物
形式
浓度
规格
纯化类型
保存液
内含物
保存条件
运输条件
产品详细信息
This antibody detects both monomer (27-30 kDa) and dimer forms of GSTO1 (54-64 kDa).
Immunogen sequence: MSGESARSL GKGSAPPGPV PEGSIRIYSM RFCPFAERTR LVLKAKGIRH EVININLKNK PEWFFKKNPF GLVPVLENSQ GQLIYESAIT CEYLDEAYPG KKLLPDDPYE KACQKMILEL FSKVPSLVGS FIRSQNKEDY AGLKEEFRKE FTKLEEVLTN KKTTFFGGNS ISMIDYLIWP WFERLEAMKL NECVDHTPKL KLWMAAMKED PTVSALLTSE KDWQGFLELY LQNSPEACDY GL (1-241 aa encoded by BC000127)
靶标信息
The protein encoded by this gene is an omega class glutathione S-transferase (GST) with glutathione-dependent thiol transferase and dehydroascorbate reductase activities. GSTs are involved in the metabolism of xenobiotics and carcinogens. The encoded protein acts as a homodimer and is found in the cytoplasm. Three transcript variants encoding different isoforms have been found for this gene.
仅用于科研。不用于诊断过程。未经明确授权不得转售。
生物信息学
蛋白别名: epididymis secretory protein Li 21; glutathione S-transferase like; Glutathione S-transferase omega 1-1; Glutathione S-transferase omega-1; Glutathione transferase omega 1 (GSTO 1-1) (p28); Glutathione-dependent dehydroascorbate reductase; glutathione-S-transferase like; GSTO 1-1; GSTO-1; MMA(V) reductase; Monomethylarsonic acid reductase; p28; RP11-99N20.1; S-(Phenacyl)glutathione reductase; SPG-R; unnamed protein product
基因别名: AA407097; AI194287; AU018802; GSTO 1-1; GSTO1; GSTTLP28; GSTX; Gtsttl; HEL-S-21; P28; SPG-R
UniProt ID: (Human) P78417, (Mouse) O09131
Entrez Gene ID: (Human) 9446, (Rat) 114846, (Mouse) 14873